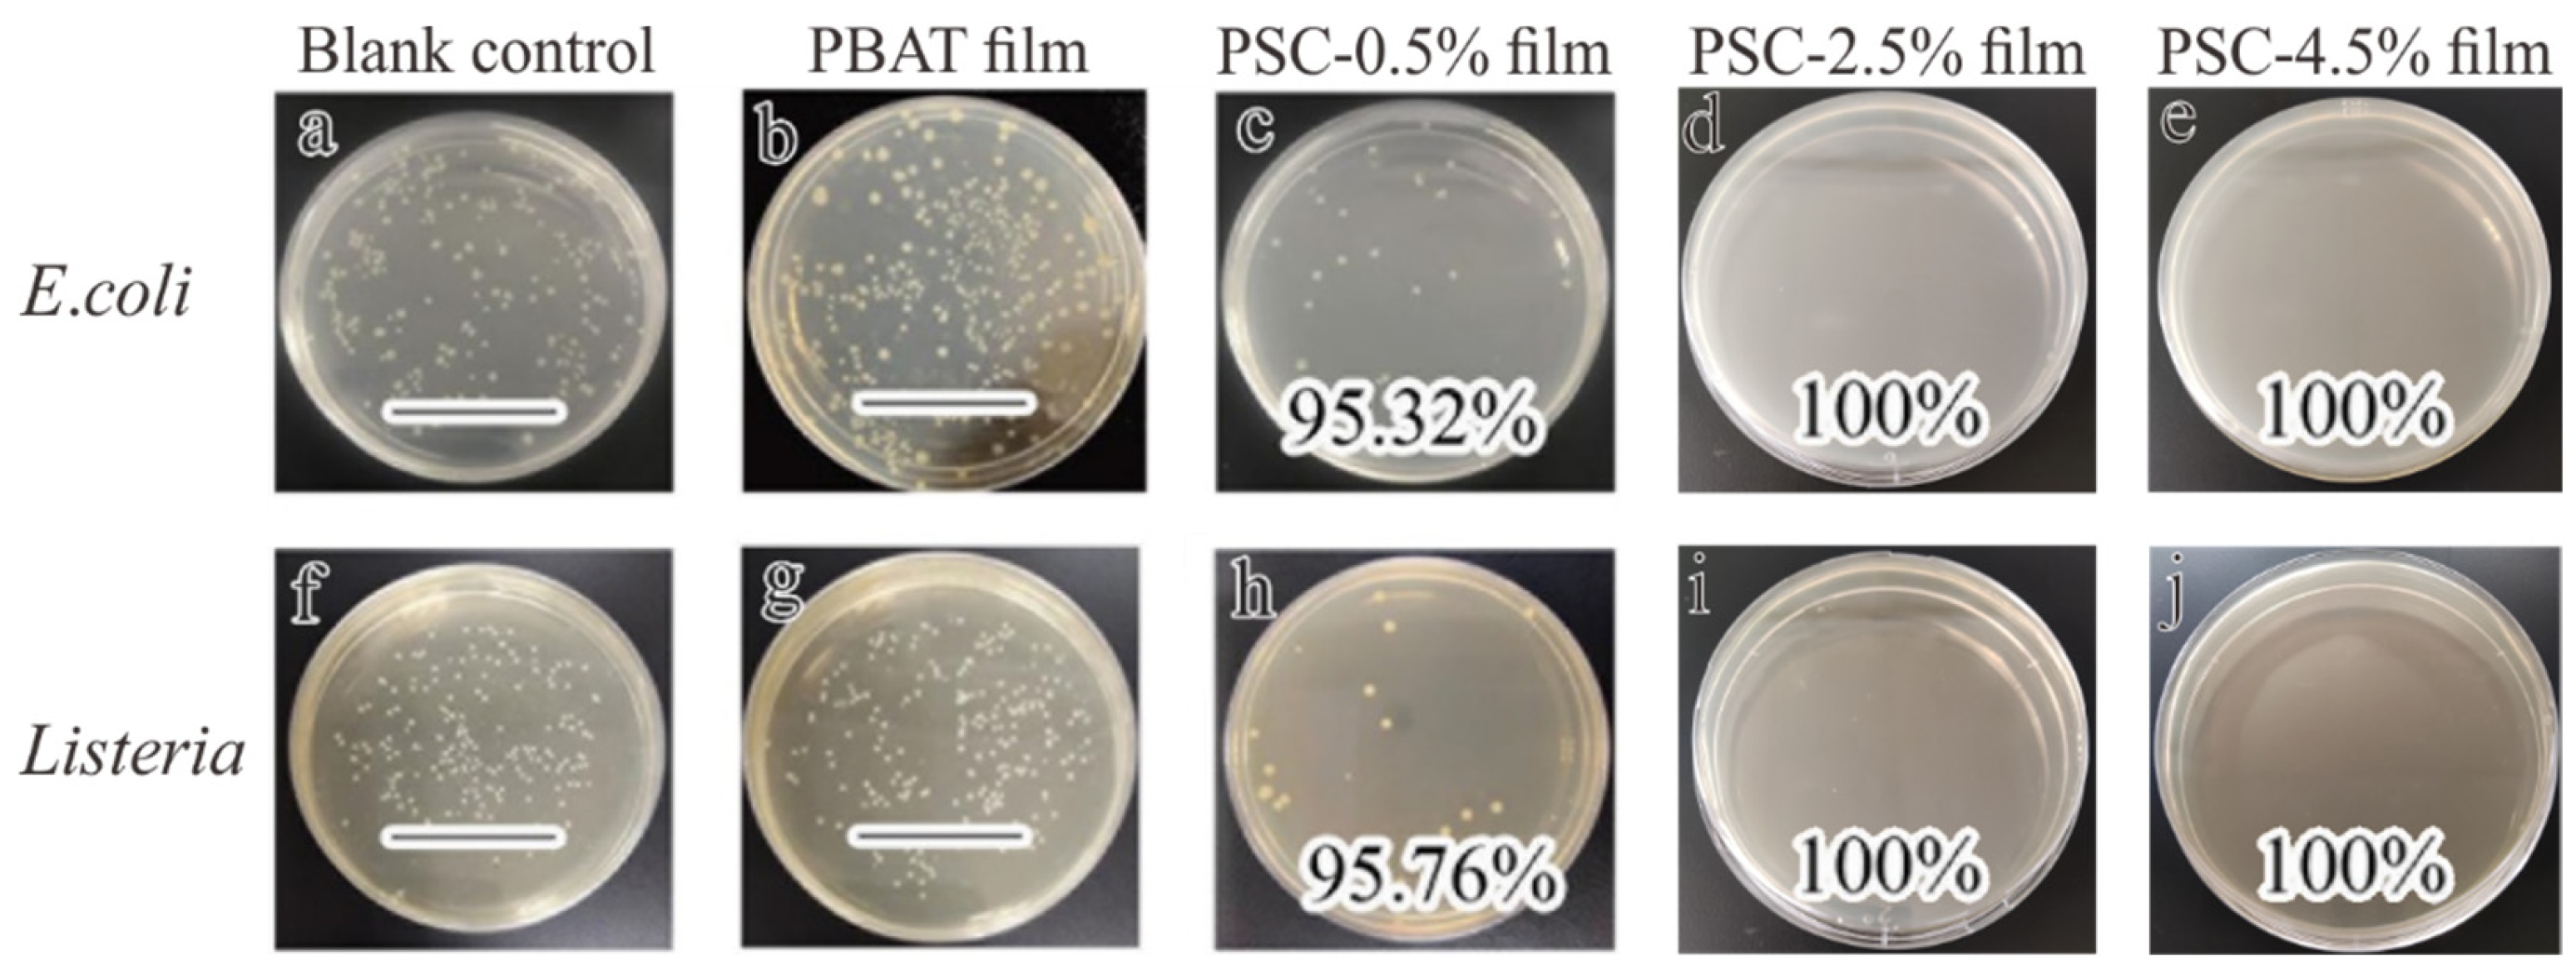
Processes 08 00897 g010

Preparation of Long-Term Antibacterial SiO2-Cinnamaldehyde Microcapsule via Sol-Gel Approach as a Functional Additive for PBAT Film
Abstract
:1. Introduction
2. Materials and Methods
2.1. Materials and Regents
2.2. Preparation and Characterization of Microcapsules
2.2.1. Preparation of Microcapsules
2.2.2. Characterizations of Microcapsules
2.2.3. Encapsulation Efficiency
2.2.4. Sustained-Release Performance of Microcapsules
2.2.5. Antibacterial Assay of Microcapsules
2.3. Preparation and Characterization of Microcapsules Loaded Films
2.3.1. Preparation of Films
2.3.2. Characterization of Films
2.3.3. Antibacterial Assay of Films
2.4. Statistical Analysis
3. Results and Discussion
3.1. Preparation of Microcapsules
3.1.1. Preparation
3.1.2. Effect of CA Concentration on Encapsulation Efficiency
3.2. Structural and Morphological Properties of Microcapsules
3.2.1. Functional Structure
3.2.2. Crystallography
3.2.3. Surface Morphology
3.3. Sustained-Release Performance Analysis
3.4. Antibacterial Activity Analysis
3.5. Modification Effect of Microcapsule on Films
3.5.1. Physical Properties of Films
3.5.2. Thermodynamic Properties of Films
3.5.3. Surface Morphology of Films
3.5.4. Antibacterial Properties of Films
4. Conclusions
Supplementary Materials
Author Contributions
Funding
Acknowledgments
Conflicts of Interest
References
- Elgayyar, M.; Draughon, F.A.; Golden, D.A.; Mount, J.R. Antimicrobial activity of essential oils from plants against selected pathogenic and saprophytic microorganisms. J. Food Prot. 2001, 64, 1019–1024. [Google Scholar] [CrossRef]
- Shankar, S.; Rhim, J.W. Effect of types of zinc oxide nanoparticles on structural, mechanical and antibacterial properties of poly(lactide)/poly(butylene adipate-co-terephthalate) composite films. Food Packag. Shelf Life 2019, 21, 100327. [Google Scholar] [CrossRef]
- Shiroodi, S.G.; Nesaei, S.; Ovissipour, M.; Al-Qadiri, H.M.; Rasco, B.; Sablani, S. Biodegradable Polymeric Films Incorporated with Nisin: Characterization and Efficiency against Listeria monocytogenes monocytogenes. Food Bioprocess Technol. 2016, 9, 958–969. [Google Scholar] [CrossRef]
- Khaneghah, A.M.; Hashemi, S.M.B.; Limbo, S. Antimicrobial agents and packaging systems in antimicrobial active food packaging: An overview of approaches and interactions. Food Bioprod. Process. 2018, 111, 1–19. [Google Scholar] [CrossRef]
- Cardoso, L.G.; Santos, J.C.P.; Camilloto, G.P.; Miranda, A.L.; Druzian, J.I.; Guimardes, A.G. Development of active films poly (butylene adipate co-terephthalate)—PBAT incorporated with oregano essential oil and application in fish fillet preservation. Ind. Crops Prod. 2017, 108, 388–397. [Google Scholar] [CrossRef]
- Friedman, M.; Henika, P.R.; Mandrell, R.E. Bactericidal activities of plant essential oils and some of their isolated constituents against Campylobacter jejuni, Escherichia coli, Listeria monocytogenes monocytogenes, and Salmonella enterica. J. Food Prot. 2002, 65, 1545–1560. [Google Scholar] [CrossRef] [PubMed]
- Ghani, S.; Barzegar, H.; Noshad, M.; Hojjati, M. The preparation, characterization and in vitro application evaluation of soluble soybean polysaccharide films incorporated with cinnamon essential oil nanoemulsions. Int. J. Biol. Macromol. 2018, 112, 197–202. [Google Scholar] [CrossRef] [PubMed]
- Shreaz, S.; Wani, W.A.; Behbehani, J.M.; Raja, V.; Irshad, M.; Karched, M.; Ali, I.; Siddiqi, W.A.; Hun, L.T. Cinnamaldehyde and its derivatives, a novel class of antifungal agents. Fitoterapia 2016, 112, 116–131. [Google Scholar] [CrossRef] [PubMed]
- Uzunlu, S.; Niranjan, K. Laboratory antimicrobial activity of cinnamaldehyde and pomegranate-based polycaprolactone films. J. Appl. Polym. Sci. 2017, 134, 45347. [Google Scholar] [CrossRef]
- Munhuweyi, K.; Caleb, O.J.; van Reenen, A.J.; Opara, U.L. Physical and antifungal properties of beta-cyclodextrin microcapsules and nanofibre films containing cinnamon and oregano essential oils. Lwt-Food Sci. Technol. 2018, 87, 413–422. [Google Scholar] [CrossRef]
- Lisuzzo, L.; Cavallaro, G.; Milioto, S.; Lazzara, G. Layered composite based on halloysite and natural polymers: A carrier for the pH controlled release of drugs. New J. Chem. 2019, 43, 10887–10893. [Google Scholar] [CrossRef]
- Guo, X.Z.; Zhang, Q.L.; Ding, X.G.; Shen, Q.H.; Wu, C.C.; Zhang, L.J.; Yang, H. Synthesis and application of several sol-gel-derived materials via sol-gel process combining with other technologies: A review. J. Sol-Gel Sci. Technol. 2016, 79, 328–358. [Google Scholar] [CrossRef]
- Vallet-Regi, M.; Ramila, A.; del Real, R.P.; Perez-Pariente, J. A new property of MCM-41: Drug delivery system. Chem. Mater. 2001, 13, 308–311. [Google Scholar] [CrossRef]
- Xue, J.M.; Shi, M. PLGA/mesoporous silica hybrid structure for controlled drug release. J. Control Release 2004, 98, 209–217. [Google Scholar] [CrossRef] [PubMed]
- Meaney, S.P.; Tabor, R.F.; Follink, B. Synthesis and characterisation of robust emulsion-templated silica microcapsules. J. Colloid Interface Sci. 2017, 505, 664–672. [Google Scholar] [CrossRef]
- Wells, C.; Vollin-Bringel, O.; Fiegel, V.; Harlepp, S.; Van der Schueren, B.; Begin-Colin, S.; Begin, D.; Mertz, D. Engineering of Mesoporous Silica Coated Carbon-Based Materials Optimized for an Ultrahigh Doxorubicin Payload and a Drug Release Activated by pH, T, and NIR-light. Adv. Funct. Mater. 2018, 28, 1706996. [Google Scholar] [CrossRef]
- Ji, Q.M.; Qiao, X.; Liu, X.B.; Jia, H.B.; Yu, J.S.; Ariga, K. Enhanced Adsorption Selectivity of Aromatic Vapors in Carbon Capsule Film by Control of Surface Surfactants on Carbon Capsule. B Chem. Soc. Jpn. 2018, 91, 391–397. [Google Scholar] [CrossRef]
- Bastarrachea, L.; Dhawan, S.; Sablani, S.S.; Mah, J.H.; Kang, D.H.; Zhang, J.W.; Tang, J. Biodegradable Poly(butylene adipate-co-terephthalate) Films Incorporated with Nisin: Characterization and Effectiveness against Listeria monocytogenes innocua. Int. J. Food Sci. Nutr. 2010, 75, E215–E224. [Google Scholar] [CrossRef]
- Ferreira, F.V.; Cividanes, L.S.; Gouveia, R.F.; Lona, L.M.F. An overview on properties and applications of poly(butylene adipate-co-terephthalate)-PBAT based composites. Polym. Eng. Sci. 2019, 59, E7–E15. [Google Scholar] [CrossRef]
- Li, W.L.; Coffin, D.R.; Jin, T.Z.; Latona, N.; Liu, C.K.; Liu, B.; Zhang, J.W.; Liu, L.S. Biodegradable composites from polyester and sugar beet pulp with antimicrobial coating for food packaging. J. Appl. Polym. Sci. 2012, 126, E361–E372. [Google Scholar] [CrossRef]
- Nofar, M.; Tabatabaei, A.; Sojoudiasli, H.; Park, C.B.; Carreau, P.J.; Heuzey, M.C.; Kamal, M.R. Mechanical and bead foaming behavior of PLA-PBAT and PLA-PBSA blends with different morphologies. Eur. Polym. J. 2017, 90, 231–244. [Google Scholar] [CrossRef]
- Shankar, S.; Rhim, J.W. Preparation of antibacterial poly(lactide)/poly(butylene adipate-co-terephthalate) composite films incorporated with grapefruit seed extract. Int. J. Biol. Macromol. 2018, 120, 846–8524. [Google Scholar] [CrossRef]
- Thiyagu, T.T.; Rajeswari, N. Effect of nanosilica and neem tree oil on antimicrobial, thermal, mechanical and electrical insulate of biodegradable composite film. Mater. Res. Express 2019, 6, 095410. [Google Scholar] [CrossRef]
- Alarcon-Moyano, J.K.; Bustos, R.O.; Herrera, M.L.; Matiacevich, S.B. Alginate edible films containing microencapsulated lemongrass oil or citral: Effect of encapsulating agent and storage time on physical and antimicrobial properties. J. Food Sci. Technol. 2017, 54, 2878–2889. [Google Scholar] [CrossRef]
- Barrett, E.P.; Joyner, L.G.; Halenda, P.P. The determination of pore volume and area distributions in porous substances. I. Computations from nitrogen isotherms. J. Am. Chem. Soc. 1951, 73, 373–380. [Google Scholar] [CrossRef]
- Matshetshe, K.I.; Parani, S.; Manki, S.M.; Oluwafemi, O.S. Preparation, characterization and in vitro release study of beta-cyclodextrin/chitosan nanoparticles loaded Cinnamomum zeylanicum essential oil. Int. J. Biol. Macromol. 2018, 118, 676–682. [Google Scholar] [CrossRef]
- Wu, J.L.; Liu, H.; Ge, S.Y.; Wang, S.; Qin, Z.Q.; Chen, L.; Zheng, Q.H.; Liu, Q.Y.; Zhang, Q.Q. The preparation, characterization, antimicrobial stability and in vitro release evaluation of fish gelatin films incorporated with cinnamon essential oil nanoliposomes. Food Hydrocoll. 2015, 43, 427–435. [Google Scholar] [CrossRef]
- Li, J.R.; Zou, J.; Xiao, H.N.; He, B.H.; Hou, X.B.; Qian, L.Y. Preparation of novel nano-sized hydrogel microcapsules via layer-by-layer assembly as delivery vehicles for drugs onto hygiene paper. Polym.-Basel 2018, 10, 335. [Google Scholar] [CrossRef]
- Moghimi, R.; Aliahmadi, A.; Rafati, H. Antibacterial hydroxypropyl methyl cellulose edible films containing nanoemulsions of thymus daenensis essential oil for food packaging. Carbohydr. Polym. 2017, 175, 241–248. [Google Scholar] [CrossRef]
- Zhang, S.C.; Chen, Y.; Campagne, C.; Salaun, F. Influence of a coaxial electrospraying system on the n-hexadecane/polycaprolactone phase change microcapsules properties. Materials 2020, 13, 2205. [Google Scholar] [CrossRef]
- Huang, C.X.; Zhang, B.D.; Wang, S.F.; Zhang, L.Y.; Wang, J.; Huang, X.Q.; Zhao, Y.; Huang, L.J. Moisture-triggered release of self-produced ClO2 gas from microcapsule antibacterial film system. J. Mater. Sci. Technol. 2018, 53, 12704–12717. [Google Scholar] [CrossRef]
- Mohammadi, A.; Hashemi, M.; Hosseini, S.M. Chitosan nanoparticles loaded with Cinnamomum zeylanicum essential oil enhance the shelf life of cucumber during cold storage. Postharvest Biol. Technol. 2015, 110, 203–213. [Google Scholar] [CrossRef]
- Maftoonazad, N.; Shahamirian, M.; John, D.; Ramaswamy, H. Development and evaluation of antibacterial electrospun pea protein isolate-polyvinyl alcohol nanocomposite mats incorporated with cinnamaldehyde. Mater. Sci. Eng. C-Mater. 2019, 94, 393–402. [Google Scholar] [CrossRef]
- Wen, P.; Zhu, D.H.; Feng, K.; Liu, F.J.; Lou, W.Y.; Li, N.; Zong, M.H.; Wu, H. Fabrication of electrospun polylactic acid nanofilm incorporating cinnamon essential oil/beta-cyclodextrin inclusion complex for antimicrobial packaging. Food Chem. 2016, 196, 996–1004. [Google Scholar] [CrossRef]
- Elfeky, S.A.; Mahmoud, S.E.; Youssef, A.F. Applications of CTAB modified magnetic nanoparticles for removal of chromium (VI) from contaminated water. J. Adv. Res. 2017, 8, 435–443. [Google Scholar] [CrossRef]
- Corradini, C.; Alfieri, I.; Cavazza, A.; Lantano, C.; Lorenzi, A.; Zucchetto, N.; Montenero, A. Antimicrobial films containing lysozyme for active packaging obtained by sol-gel technique. J. Food Eng. 2013, 119, 580–587. [Google Scholar] [CrossRef]
- Qu, Q.Q.; Wang, H.; He, J.; Su, Z.; Qin, T.F.; Tian, X.Y. Preparation and characterization of temperature-triggered silica microcapsules containing sodium monofluorophosphate with tolerability to extreme pH. Colloid Surf. A 2019, 564, 152–160. [Google Scholar] [CrossRef]
- Lee, M.H.; Seo, H.S.; Park, H.J. Thyme oil encapsulated in halloysite nanotubes for antimicrobial packaging system. J. Food Sci. 2017, 82, 922–932. [Google Scholar] [CrossRef]
- Duan, B.; Chang, C.Y.; Ding, B.B.; Cai, J.; Xu, M.; Feng, S.C.; Ren, J.Z.; Shi, X.W.; Du, Y.M.; Zhang, L.N. High strength films with gas-barrier fabricated from chitin solution dissolved at low temperature. J. Mater. Chem. A 2013, 1, 1867–1874. [Google Scholar] [CrossRef]
- Wu, C.H.; Zhu, Y.; Wu, T.T.; Wang, L.; Yuan, Y.; Chen, J.C.; Hu, Y.Q.; Pang, J. Enhanced functional properties of biopolymer film incorporated with curcurmin-loaded mesoporous silica nanoparticles for food packaging. Food Chem. 2019, 288, 139–145. [Google Scholar] [CrossRef]
- Liu, P.B.; Huang, Y.; Yan, J.; Yang, Y.W.; Zhao, Y. Construction of CuS Nanoflakes Vertically Aligned on Magnetically Decorated Graphene and Their Enhanced Microwave Absorption Properties. ACS Appl. Mater. Interfaces 2016, 8, 5536–5546. [Google Scholar] [CrossRef] [PubMed]
- Ke, J.X.; Xiao, L.Y.; Yu, G.X.; Wu, H.J.; Shen, G.H.; Zhang, Z.Q. The study of diffusion kinetics of cinnamaldehyde from corn starch-based film into food simulant and physical properties of antibacterial polymer film. Int. J. Biol. Macromol. 2019, 125, 642–650. [Google Scholar] [CrossRef] [PubMed]
- Ueoka, H.; Shimomura, O.; Ueda, K.; Inada, K.; Nomura, R. Release behavior of a polyanion-crosslinked chitosan-poly(N-isopropylacrylamide) gel thermoresponsive material. J. Appl. Polym. Sci. 2018, 135, 46732. [Google Scholar] [CrossRef]
- Balaguer, M.P.; Borne, M.; Chalier, P.; Gontard, N.; Morel, M.H.; Peyron, S.; Gavara, R.; Hernandez-Munoz, P. Retention and Release of Cinnamaldehyde from Wheat Protein Matrices. Biomacromolecules 2013, 14, 1493–1502. [Google Scholar] [CrossRef]
- Herrera, A.; Rodriguez, F.J.; Bruna, J.E.; Abarca, R.L.; Galotto, M.J.; Guarda, A.; Mascayano, C.; Sandoval-Yanze, C.; Padula, M.; Felipe, F.R.S. Antifungal and physicochemical properties of inclusion complexes based on beta-cyclodextrin and essential oil derivatives. Food Res. Int. 2019, 121, 127–135. [Google Scholar] [CrossRef]
- Khaled, S.A.; Burley, J.C.; Alexander, M.R.; Yang, J.; Roberts, C.J. 3D printing of tablets containing multiple drugs with defined release profiles. Int. J. Pharm. 2015, 494, 643–650. [Google Scholar] [CrossRef]
- Dima, C.; Patrascu, L.; Cantaragiu, A.; Alexe, P.; Dima, S. The kinetics of the swelling process and the release mechanisms of Coriandrum sativum L. essential oil from chitosan/alginate/inulin microcapsules. Food Chem. 2016, 195, 39–48. [Google Scholar] [CrossRef]
- El-Hamshary, H.; El-Newehy, M.H.; Abdulhameed, M.M.; El-Faham, A.; Elsherbiny, A.S. Evaluation of clay-ionene nanocomposite carriers for controlled drug delivery: Synthesis, in vitro drug release, and kinetics. Mater. Chem. Phys. 2019, 225, 122–132. [Google Scholar] [CrossRef]
- Helander, I.M.; Alakomi, H.L.; Latva-Kala, K.; Mattila-Sandholm, T.; Pol, I.; Smid, E.J.; Gorris, L.G.M.; von Wright, A. Characterization of the action of selected essential oil components on gram-negative bacteria. J. Agric. Food Chem. 1998, 46, 3590–3595. [Google Scholar] [CrossRef]
- Sanla-Ead, N.; Jangchud, A.; Chonhenchob, V.; Suppakul, P. Antimicrobial Activity of Cinnamaldehyde and Eugenol and Their Activity after Incorporation into Cellulose-based Packaging Films. Packag. Technol. Sci. 2012, 25, 7–17. [Google Scholar] [CrossRef]
- Corrales, M.; Han, J.H.; Tauscher, B. Antimicrobial properties of grape seed extracts and their effectiveness after incorporation into pea starch films. Int. J Food Sci. Technol. 2009, 44, 425–433. [Google Scholar] [CrossRef]
- Zhang, F.F.; Bai, X.P.; Wei, G.; Wang, G.D.; Shi, Z.Z.; Jun, C. Effects of virgin coconut oil on the physicochemical, morphological and antibacterial properties of potato starch-based biodegradable films. Int. J. Food Sci. Technol. 2020, 55, 192–200. [Google Scholar]
- Chen, G.Q.; Scholes, C.A.; Doherty, C.M.; Hill, A.J.; Qiao, G.G.; Kentish, S.E. The thickness dependence of Matrimid films in water vapor permeation. Chem. Eng. J. 2012, 209, 301–312. [Google Scholar] [CrossRef]
- Khorasani, M.T.; Joorabloo, A.; Moghaddam, A.; Shamsi, H.; MansooriMoghadam, Z. Incorporation of ZnO nanoparticles into heparinised polyvinyl alcohol/chitosan hydrogels for wound dressing application. Int. J. Biol. Macromol. 2018, 114, 1203–1215. [Google Scholar] [CrossRef] [PubMed]
- Sun, X.X.; Wang, Z.; Kadouh, H.; Zhou, K.Q. The antimicrobial, mechanical, physical and structural properties of chitosan-gallic acid films. Lwt-Food Sci. Technol. 2014, 57, 83–89. [Google Scholar] [CrossRef]
- Xiao, M.; Gu, S.; Zhu, P.C.; Tang, M.Y.; Zhu, W.D.; Lin, R.X.; Chen, C.L.; Xu, W.C.; Yu, T.; Zhu, J. Tin-Based Perovskite with Improved Coverage and Crystallinity through Tin-Fluoride-Assisted Heterogeneous Nucleation. Adv. Opt. Mater. 2018, 6, 1700615. [Google Scholar] [CrossRef]
- Olewnik-Kruszkowska, E.; Tarach, I.; Richert, A.; Cichosz, M.; Koter, I.; Nowaczyk, J. Physicochemical and barrier properties of polylactide films including antimicrobial additives. Mater. Chem. Phys. 2019, 230, 299–307. [Google Scholar] [CrossRef]
- Liu, J.; Li, J.F.; Luo, Z.P.; Liu, Y.B.; Liu, Z.X.; Chen, Z.C.; Ren, Y.F.; Zhu, B.L.; Wang, R.M.; Zhang, Q.Y. A novel multiwalled LiF@GO@SiO2 microcapsule with high phase change temperature. Sol. Energy Mater. Sol. Cells 2019, 203, 110188. [Google Scholar] [CrossRef]
- Moreno, M.A.; Orqueda, M.E.; Gomez-Mascaraque, L.G.; Isla, M.I.; Lopez-Rubio, A. Crosslinked electrospun zein-based food packaging coatings containing bioactive chilto fruit extracts. Food Hydrocoll. 2019, 95, 496–505. [Google Scholar] [CrossRef]

| Equation Model | Release Condition | Fitting Equation | R2 | |
|---|---|---|---|---|
| 90%RH | 4 °C | Q = 55.1637 (1 × 10−0.0555t) | 0.9835 | |
| 23 °C | Q = 74.1331 (1× 10−0.0618t) | 0.9438 | ||
| 40 °C | Q = 87.7758 (1 × 10−0.08t) | 0.9751 | ||
| 40 °C | 50%RH | Q = 75.7937 (1 × 10−0.0465t) | 0.9867 | |
| 70%RH | Q = 84.2127 (1 × 10−0.0480t) | 0.9934 | ||
| 90%RH | Q = 87.7758 (1 × 10−0.08t) | 0.9751 | ||
| Concentration (mg·mL−1) | Inhibition Zone Diameter (mm) | |
|---|---|---|
| ListeriaMonocytogenes | E. coli | |
| Blank control | -- | -- |
| Negative control | -- | -- |
| 40 | 12.55 | -- |
| 50 | 12.70 | -- |
| 60 | 12.74 | -- |
| 70 | 12.89 | -- |
| 80 | 13.26 | 11.08 |
| 90 | 13.95 | 11.99 |
| Sample | Tonset (°C) | Tc (°C) | Tm (°C) | Xc (%) |
|---|---|---|---|---|
| PBAT film | 92.91 | 61.54 | 123.13 | 11.12 |
| PSC-0.5% film | 94.20 | 66.44 | 124.06 | 11.22 |
| PSC-2.5% film | 94.65 | 70.25 | 123.49 | 11.67 |
| PSC-4.5% film | 92.67 | 70.21 | 123.28 | 10.10 |
© 2020 by the authors. Licensee MDPI, Basel, Switzerland. This article is an open access article distributed under the terms and conditions of the Creative Commons Attribution (CC BY) license (http://creativecommons.org/licenses/by/4.0/).
Share and Cite
Xu, Y.; Huang, C.; Dang, X.; Khan, M.R.; Huang, H.; Zhao, Y.; Wang, S. Preparation of Long-Term Antibacterial SiO2-Cinnamaldehyde Microcapsule via Sol-Gel Approach as a Functional Additive for PBAT Film. Processes 2020, 8, 897. https://doi.org/10.3390/pr8080897
Xu Y, Huang C, Dang X, Khan MR, Huang H, Zhao Y, Wang S. Preparation of Long-Term Antibacterial SiO2-Cinnamaldehyde Microcapsule via Sol-Gel Approach as a Functional Additive for PBAT Film. Processes. 2020; 8(8):897. https://doi.org/10.3390/pr8080897
Chicago/Turabian StyleXu, Yangfan, Chongxing Huang, Xiujie Dang, Muhammad Rafiullah Khan, Haohe Huang, Yuan Zhao, and Shuangfei Wang. 2020. "Preparation of Long-Term Antibacterial SiO2-Cinnamaldehyde Microcapsule via Sol-Gel Approach as a Functional Additive for PBAT Film" Processes 8, no. 8: 897. https://doi.org/10.3390/pr8080897
APA StyleXu, Y., Huang, C., Dang, X., Khan, M. R., Huang, H., Zhao, Y., & Wang, S. (2020). Preparation of Long-Term Antibacterial SiO2-Cinnamaldehyde Microcapsule via Sol-Gel Approach as a Functional Additive for PBAT Film. Processes, 8(8), 897. https://doi.org/10.3390/pr8080897







